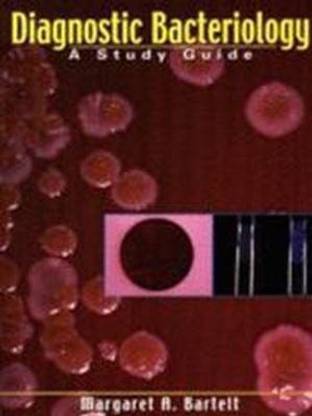
Diagnostic Bacteriology

Diagnostic Bacteriology (English, Paperback, Bartelt Margaret A.)
Price: Not Available
Currently Unavailable
Highlights
- Language: English
- Binding: Paperback
- Publisher: F.A. Davis Company
- Genre: Medical
- ISBN: 9780803603011, 9780803603011
- Pages: 277
Description
Organized in a concise, simplified manner using an outline format to organize the material, this text emphasizes the role of the clinical microbiology laboratory in diagnosing and treating diseases. Bacteria (e.g., gram-positive, anaerobic, etc.) and laboratory procedures (e.g., antimicrobial agents and susceptibility tests) are clustered in seven unique sections. Chapter study questions and a 100-question comprehensive exam are included.
Read More
Specifications
Book Details
| Imprint |
|
Dimensions
| Width |
|
| Height |
|
| Length |
|
Be the first to ask about this product
Safe and Secure Payments.Easy returns.100% Authentic products.
Back to top




